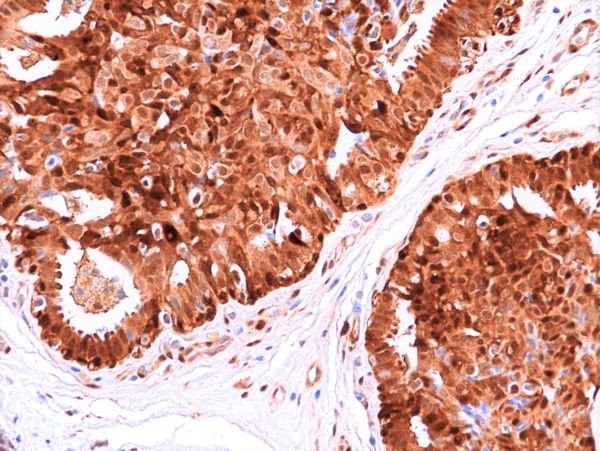

Search
Invitrogen
HSP70 Recombinant Rabbit Monoclonal Antibody (RM432)
{{$productOrderCtrl.translations['antibody.pdp.commerceCard.promotion.promotions']}}
{{$productOrderCtrl.translations['antibody.pdp.commerceCard.promotion.viewpromo']}}
{{$productOrderCtrl.translations['antibody.pdp.commerceCard.promotion.promocode']}}: {{promo.promoCode}} {{promo.promoTitle}} {{promo.promoDescription}}. {{$productOrderCtrl.translations['antibody.pdp.commerceCard.promotion.learnmore']}}
产品信息
MA562132
种属反应
宿主/亚型
Expression System
分类
类型
克隆号
抗原
偶联物
形式
浓度
纯化类型
保存液
内含物
保存条件
运输条件
RRID
产品详细信息
This antibody reacts to human HSP70.
靶标信息
HSP70 is a Heat shock protein (HSP) which are expressed in response to various biological stresses, including high temperatures. There are several major families of HSPs that include HSP70, there are HSP90 and HSP100. The HSP70 family is a set of highly conserved proteins that are induced by a variety of biological stresses, including heat stress, in every organism in which the proteins have been examined. The human HSP70 family members include: HSP70, a protein which is strongly inducible in all organisms but which is also constitutively expressed in primate cells; HSP72, a 72 kDa protein that is induced exclusively under stress conditions; HSC70, or cognate protein, is a 72 kDa, constitutively expressed, protein which is involved in the uncoating of clathrin coated vesicles; GRP78, or BiP, is a glucose regulated 78 kDa protein localized in the endoplasmic reticulum; and p75, or HSP75, a 75 kDa protein that is found within the mitochondria. Further, HSP70 is encoded by an intronless gene and, in conjunction with other heat shock proteins, HSP70 stabilizes existing proteins against aggregation and mediates the folding of newly translated proteins in the cytosol and organelles. HSP70 is also involved in the ubiquitin-proteasome pathway through interaction with the AU-rich element RNA-binding protein 1. The HSP70 gene is located in the major histocompatibility complex class III region, in a cluster with two closely related genes which encode similar proteins.
仅用于科研。不用于诊断过程。未经明确授权不得转售。
篇参考文献 (0)
生物信息学
蛋白别名: 70 kilodalton heat shock protein; ARABIDOPSIS HEAT SHOCK PROTEIN 70; ATHSP70; dnaK-type molecular chaperone HSP70-1; epididymis secretory protein Li 103; epididymis secretory sperm binding protein; epididymis secretory sperm binding protein Li 5a; heat shock 10kDa protein 1-like; Heat shock 70 kDa protein 1; Heat shock 70 kDa protein 1-Hom; Heat shock 70 kDa protein 1-like; heat shock 70 kDa protein 1/2; Heat shock 70 kDa protein 1A; heat shock 70 kDa protein 1A/1B; Heat shock 70 kDa protein 1B; Heat shock 70 kDa protein 1L; Heat shock 70 kDa protein 2; Heat shock 70 kDa protein 4; Heat shock 70-related protein APG-2; heat shock 70kD protein 1A; heat shock 70kD protein 1B; heat shock 70kD protein 2; heat shock 70kD protein 4; heat shock 70kD protein-like 1; heat shock 70kDa protein 1-like; heat shock 70kDa protein 1A; heat shock 70kDa protein 1B; heat shock 70kDa protein 2; Heat shock protein; heat shock protein 70; Heat shock protein family A member 1A; Heat shock protein family A member 1B; Heat shock protein family A member 1L; Heat shock protein family A member 2; Heat shock protein family H member 2; heat shock protein, 110 kDa; heat shock-induced protein; Heat shock-related 70 kDa protein 2; HEL S 103; HSP; HSP70 1; HSP70 1B; HSP70 2; HSP70 AceyltK77; hsp70 RY; HSP70-1; HSP70-1/HSP70-2; HSP70-2; HSP70-Hom; HSP70.1/HSP70.2; HSP70RY; HSPA2; HSPA4; Hspa70; unnamed protein product
基因别名: APG-2; APG2; HEL-S-103; HEL-S-5a; HS24/P52; HSP70; HSP70-1; HSP70-1A; HSP70-1B; HSP70-1L; HSP70-2; HSP70-3; HSP70-HOM; HSP70.1; HSP70.2; HSP70I; hsp70RY; HSP70T; HSP72; HSPA1; HSPA1A; HSPA1B; HSPA1L; HSPA2; HSPA4; HSPH2; HSX70; hum70t; RY
UniProt ID: (Human) P0DMV8, (Human) P34931, (Human) P54652, (Human) P34932
Entrez Gene ID: (Human) 3303, (Human) 3304, (Human) 3305, (Human) 3306, (Human) 3308